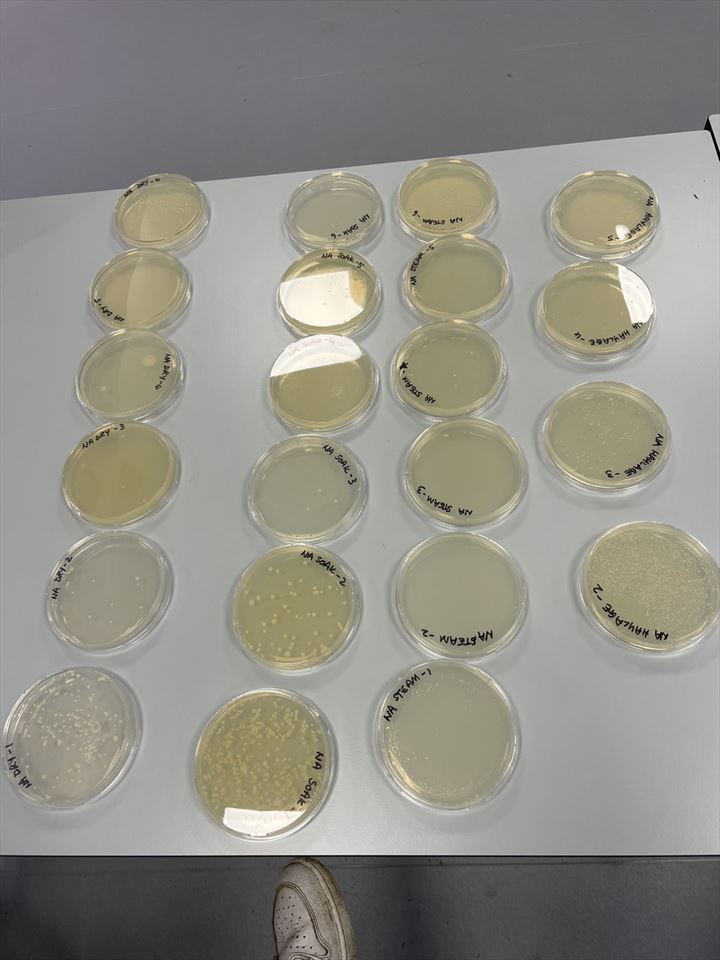

Lucia
Cirencester, Gloucestershire, UK
![]()
About
- Jobseeker No
- 437682
- Status
- Looking
- Gender/Working Couple
- Female
- Age
- 19
- Location
- Cirencester, Gloucestershire, GL7, UK
- Nationality
- UK
- Marital Status
- Single
- Occupation
- University Student
- Height
- 1.68m = 5' 6"
- Weight
- 71 kgs = 11 st 2 lb
- Smoke
- Drive
Preferences
- Live-In Position
- Bring Own Horse
- Locations
- (Gloucestershire)
- Minimum Pay
- from £10 hour
- Job Types
- General Groom
Bio
I am currently studying Equine and Bloodstock at the Royal Agricultural University. I also have my own horse at the university stables. He is a 7 year old 17.hh ex racer which I’m currently training up to be my next event horseQualifications
Currently studying Equine Sciene and Business and Bloodstock
Documents
Duties of Current Occupation
I’ve previously worked on a busy hunt yard in hunt season; included mucking out quickly, keeping everything clean, tack cleaning. Also worked on a busy livery yard (40+ horses) the duties were similar, I was given more responsibilities here.
Equine Work Experience
I’ve competed lots for the pony club when I was younger, this included festival of hunting, arena eventing, eventing and showjumping. I’ve done all my BHS challenge awards in bronze, silver and gold. In 2024 I travelled to South Africa by myself to go on a horseback safari for 2 weeks. There I learnt a lot about how different countries do their horses differently. I rode a variety of different types of horses.
Specialities
I am going on placement in April where I will start to work with foals and stallions
Type of Ride Work
I have ridden all types of horses, including young and green horses.